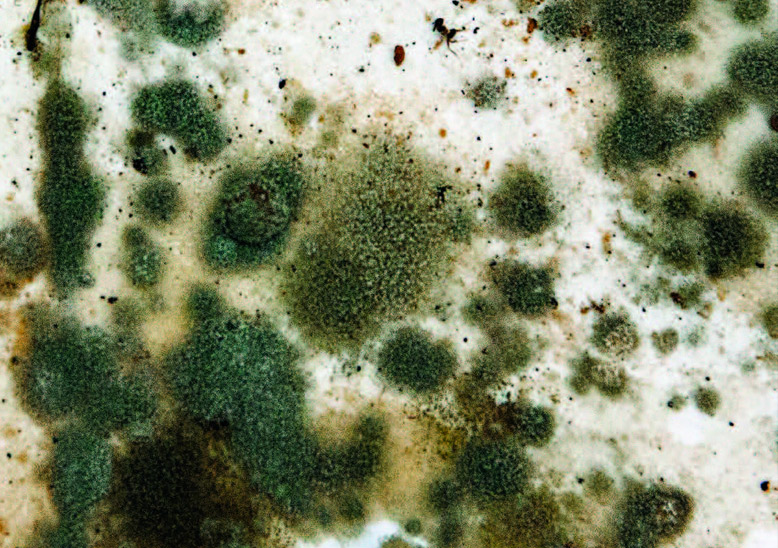
EXOTIKA

MALÍŘSKÁ KUCHAŘKA - 7. díl - REMAL PROTIPLÍSŇOVÝ
REMAL - SANACE I PREVENCE PROTI plísňím.
Vysoce funkčním řešením problematiky plísní je SYSTÉM:
REMAL Sanal na zdivo / REMAL hloubková protiplísňová penetrace / REMAL protiplísňový malířský nátěr

PROČ PREVENTIVNÍ BOJ PROTI PLÍSNÍM?
Plísně jsou skupina extrémně rychle se množících HUB - ponecháte-li je bujet, zamoří v krátké době celý byt. Opravdu, jen velice málo plísní je člověku ku prospěchu. Většina z nich je naopak pro zdraví člověka velice škodlivá, způsobuje alergické reakce a chronická onemocnění dýchací soustavy.
ČLOVĚK JE SLABŠÍ, NEŽ MINIATURNÍ HOUBA - Imunitní systém člověka je v plesnivém bytě vysílen bojem s ALERGENY - se sporami plísní. Na reakci proti dalším výzvám mu potom již nezbývá energie.
Proto je boj proti plísním zvlášť v dnešní době EXTRÉMNĚ DŮLEŽITÝ.

Objevte jednotlivé díly malířské kuchařky:
1. díl - Bílá, královna interiéru
2. díl - REMAL COLOR, Mňamóóóznííí barvičky!
3. díl - REMAL COLOR, barva MANDLE
4. díl - REMAL COLOR, Zelené jablko
5. díl - REMAL COLOR, Oranž
6. díl - REMAL COLOR, Jahoda
7. díl - REMAL PROTIPLÍSŇOVÝ
8. díl - Jako profíci... Speciál
9. díl - REMAL Vinyl
10. díl - Fasáda
11. díl - Severské odstíny
Pomůže systém speciálně vyvinutý proti plísním:

REMAL Sanal proti plísni na zdi a houbám V1406, 900 g
Přípravek proti plísni na zdi - koncentrát k dezinfekci a preventivní ochraně zdiva, omítek, kamene, betonu a jiných stavebních materiálů při napadení plísněmi a houbami.

REMAL Protiplísňový barva proti plísni
Protiplísňová barva, která vyřeší plíseň na zdi. S preventivním účinkem proti růstu plísní, hub, kvasinek, řas a bakteriím. Paropropustná, otěruvzdorná, vodouředitelná, protiplísňová barva.

REMAL hloubková penetrace protiplísňová V1311
Penetrace proti plísni preventivně omezuje tvorbu plísní díky aktivním fungicidním složkám. Pro hloubkové zpevnění podkladu, sjednocení jeho nasákavosti a zvýšení přilnavosti povrchu.

JAK SE PLÍSEŇ PROBUDÍ?
Potřebuje k životu vodu. Ve vlhkém prostředí se metabolismus houby probouzí z hibernace a začíná rychle růst.
Každá spora může vyklíčit a vytvořit novou vlastní „hyfu“ (větvovité tělo houby). Jednotlivé „houbové stromy“ se mohou spojit v jeden velký živý organismus.
Houba umí růst na povrchu, ale její hyfy jsou schopné růst a větvit se i pod povrchem, či vnitřkem zdiva (některé houby nepotřebují k životu světlo).
Houba může být i POUHÝM OKEM NA STĚNĚ ZPRVU NEVIDITELNÁ, ALE UCÍTÍTE JI. HOUBY mají svůj charakteristický ODÉR.

HOUBA DEGRADUJE ZDIVO, ZAMOŘUJE OVZDUŠÍ
Kde se HOUBA objevuje nejčastěji:
• TAM, KDE JE VLHKO, v místech bez cirkulace vzduchu.
• NEVĚTRANÉ PROSTORY, tam, kde jsou tepelné mosty srážka teplého a studeného vzduchu na povrchu zdi. Plíseň roste tam, kde je vysoká vlhkost. Zeď, která se často orosí studeným potem a vítr ji neosuší, je potom HOSTINSKÝM POKOJEM PRO HOUBY.
Příčiny výskytu:
• Stavební závady a nevhodné technické parametry objektu.
• Zatékání.
• Špatné těsnění kolem oken a dveří.
• NEDOSTATEČNÉ VĚTRÁNÍ - pára z dýchání, vaření, žehlení, bez intenzivního větrání.

PLÍSEŇ - NEJROZŠÍŘENĚJŠÍ
ŽIVOČIŠNÝ DRUH
Vědci identifi kují až 300 000 druhů existujících plísní.
Plíseň jako zázrak medicíny:
Štětičkovec nebo-li Penicillium (od roku 1939 izolován pro antibiotikum). Odhaduje se, že penicilin zachránil přes 82 milionů životů.
Plíseň v interiéru:
Podmínky pro vznik plísně jsou vlhkost a zároveň relativně nízká teplota na povrchu zdí.
Kde se vyskytuje:
na plochách a zdech, které jsou trvale vlhké, bez cirkulace vzduchu tam, kde dochází k vysrážení vlhkého vzduchu při kontaktu s chladným povrchem.

DOBA PREHISTORICKÁ
Plísně tady byly dříve, než brontosauři… jsou součástí živé přírody MILIARDY let. Rychlost růstu plísně (říkejme jejímu stromovitému tělu hyfa), je jedním z nejproduktivnějších na zemi.
Co víme o plísních?
• Miniaturní, mikroskopické vláknité HOUBY
• Základem jejich těla je HYFA a složitě se větvící podhoubí MYCELIUM
• Hyfy dosahují extrémní rychlosti růstu
• Z podhoubí vyrůstají rozmnožovací orgány a z těch se uvolňují SPORY
• Lehoučké spory (výtrusy) jsou vodoodpudivé, uvolňují se velice snadno a poletují vzduchem, potom kontaminují povrchy a předměty
• Ze spory vyklíčí vlákno, které se za příznivých podmínek rozrůstá v NOVOU HYFU. Plíseň se zároveň šíří rozrůstáním hyf či jejich úlomků i sporami

PLÍSEŇ ROSTE ZPRVU NENÁPADNĚ!
Bílé plísně
Zprvu NEVIDITELNÉ, kvůli světlé barvě na světlém povrchu dlouho obtížně identifi kovatelné. Nejčastěji na omítkách, v rozích místností, ve výklencích, za nábytkem, na vnějších stěnách nebo v suterénu. Nejprve cítíme jen plesnivý zápach nebo registrujeme přítomnost roztočů a rybenek. Zčernají až po čase - kvůli změně barvy plodného těla. Dráždí sliznice a mohou tak vyvolat infekce dutin. Tyto problémy bývají často nesprávně připisovány suchému vnitřnímu vzduchu. Pokud začneme pokoj zvlhčovat, jen tím bílé plísni poskytneme lepší podmínky k růstu.
PLÍSEŇ ZPŮSOBUJE ZDRAVOTNÍ RIZIKO…
Zelené plísně
Nejčastěji v zemědělských provozech.
Červené plísně
Milovníci celulózy - nejčastěji žijí na papírových tapetách ve vlhkých místnostech, nebo v pekárnách (výskyt v obilovinách).
Žluté plísně
Extrémně nebezpečné, objevují ve vlhkých rozích místností, na bavlněných látkách a čalouněném nábytku v našich hygienických podmínkách výskyt naštěstí vzácně.

ŘEŠENÍM
JE PREVENCE
- Větrejte často, nejméně 3x denně
- Izolujte stavbu, temperujte objekty
- Rádi uklízejte a malujte s chutí!
- Používejte barvy s preventivním protiplísňovým účinkem
KDYŽ OBJEVÍTE
PLÍSEŇ… JEDNEJTE!
ODSTRAŇTE PLÍSEŇ ZA MOKRA!
• Plíseň je potřeba nejprve navlhčit postřikem z roztoku vody a sanačního přípravku REMAL SANAL NA ZDIVO.
• Po deseti minutách působení, ještě za vlhka, seškrábněte špachtlí plísní zasaženou malbu i vrchní omítku.
• NEŠKRÁBEJTE PLÍSEŇ NA SUCHO! Dojde tím ke zbytečnému rozptýlení plísňových spor do ovzduší, ty se pak usadí na dalších místech,
kde vesele porostou…
• SANUJTE ZEĎ ještě 1-2 vrstvami nátěru přípravku REMAL SANAL NA ZDIVO, který obsahuje biocidní složky (ředění v poměru 1:9 vodou).
V případě velmi silného zasažení plísní, nebo při použití na cihlové zdivo bez omítky je možné použít silnější roztok, zředěný např. 1:5.
• PENETRUJTE – po zaschnutí 1-2 vrstev sanačního prostředku je nutné stěnu ještě napustit základním nátěrem REMAL HLOUBKOVÁ
PROTIPLÍSŇOVÁ PENETRACE. Zpevní podklad a sjednotí nasákavost vrchního nátěru, obsahuje biocid jako prevenci proti plísním.
• Po zaschnutí penetrace opravte vzniklé nerovnosti REMAL STĚRKOU. Je nádherně bílá a velice snadno brousitelná sádrokartonářskou mřížkou. Stěnu pak určitě zbavte prachu a místo opět penetrujte REMAL HLOUBKOVOU PROTIPLÍSŇOVOU PENETRACÍ.
• NAKONEC a po řádném zaschnutí penetrace - VYMALUJTE REMAL PROTIPLÍSŇOVÝM – malířskou barvou s preventivním protiplísňovým účinkem. Složení této barvy obsahuje látky zabraňující růstu plísní.
VYMEŤTE PAVOUKY…. VPUSŤTE ČERSTVÝ VZDUCH! PROFOUKNĚTE PŘÍVOD ENERGIE!
Po zlikvidování plísně a vymalování jedné místnosti jste na začátku. Využijte entuziazmu a rozplánujte si velký úklid…
• Rozdělte si práci do jednotlivých dílů a dnů.
• Projděte celý byt místnost po místnosti a sepište seznam oprav a změn.
• Začněte místností, která je nejméně reprezentativní, práci tak zcela jistě dokončíte.
• Zlikvidujte věci, které nepoužíváte.
• Vyperte záclony, umyjte oka, vpusťte si do bytu sluneční světlo a čerstvý vzduch.
SOUHRN FAKTŮ…
• Kondenzace vody na zdech interiéru a následně výskyt plísní bude tam, kde necirkuluje vzduch a kde je zároveň chladný povrch, většinou pod 12 °C. Nejčastěji v rozích místností, pod okenním parapetem, za skříněmi, kuchyňskou linkou a podobně.
• Druhým problémem souvisejícím s výskytem plísní může být defekt stavby, který je nutné odborně odstranit - špatná izolace objektu..












































